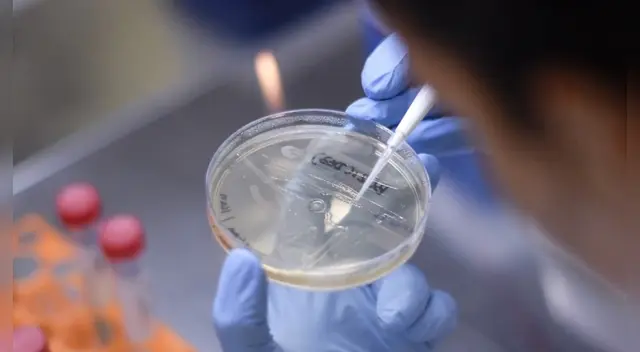
Aún hay esperanzas de que los ensayos de la vacuna para combatir el covid-19 se producirán entre 12 a 18 meses, indicó Berkley. Aún hay esperanzas de que los ensayos de la vacuna para combatir el covid-19 se producirán entre 12 a 18 meses, indicó Berkley.

Alianza Mundial para Vacunas: "No sabemos si podremos lograr una para el coronavirus"
"Soy bastante optimista, por lo que sé de la ciencia, pero no tenemos ninguna certeza sobre el concepto", afirmó el jefe de la Alianza Mundial para Vacunas e Inmunización, Seth Berkley, sobre la vacuna del coronavirus.
Únete al canal de Whatsapp de El Popular- Confirmado | Exigen el retiro urgente de este pescado de los supermercados por ser un riesgo mortal para la población
- ALARMA en Walmart: ICE se burló y arrestó a padre de familia que huyó de la guerra de Ucrania hacia EE.UU.
El jefe de la Alianza mundial de vacunas, (GAVI), Seth Berkley, afirmó que la vacuna contra la pandemia del coronavirus, que mató a más de 200.000 personas, será una lucha científica, pero no tiene la certeza de que se hallará la cura para la mortal pandemia.
"Uno de los desafíos es que no sabemos si podremos hacer una vacuna. Soy bastante optimista, por lo que sé de la ciencia, pero no tenemos ninguna certeza sobre el concepto de ese remedio. ", se sinceró Berkley en una rueda de prensa virtual en Ginebra.
Asimismo, el representante indicó que una vacuna tarda en desarrollarse de 10 hasta 15 años, pero aún hay esperanzas de que los ensayos de la vacuna para combatir el covid-19 se producirán entre 12 a 18 meses "si tenemos mucha suerte".
"La competencia es grande", dijo Berkley, explicando que, hasta el momento hay más de 100, y posiblemente hasta 150 vacunas diferentes en varias etapas de desarrollo que compiten por ser los primeros en obtener la cura de la letal enfermedad.
"Las vacilaciones en torno a la vacunación se debe al hecho que las vacunas son tan efectivas que las enfermedades han desaparecido en algunos países, como la fiebre amarilla o el tétanos”, explicó Berkley sobre el fenómeno antivacunación en varios países occidentales.
Cabe resaltar que el coronavirus ha logrado infectar a más de 2.7 millones de personas en todo el mundo, siendo el país más afectado Estados Unidos que tiene casi un millón de infectados y las muertes superan los 50 mil en el país norteamericano.
Científicos chinos experimentaron con éxito en monos la vacuna contra el coronavirus
Una vacuna experimental contra el coronavirus desarrollado por un grupo de científicos en China ha logrado obtener buenos resultados, después de probarlo en monos y logrando eliminar el virus por completo, según afirmó este viernes un laboratorio chino.
"Los cuatro monos que recibieron la vacuna en una dosis alta no tenían ningún rastro del virus en los pulmones siete días después de su contaminación", explicó el laboratorio chino que llevó a cabo el experimento.